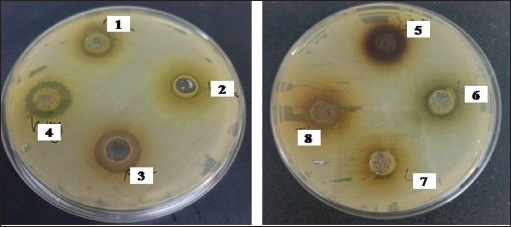
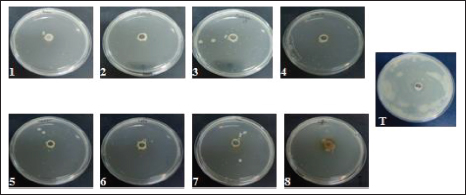

| Research Article | ||
Open Vet. J.. 2023; 13(9): 1082-1090 Open Veterinary Journal, (2023), Vol. 13(9): 1082–1090 Original Research Inhibitory potential of natural plant extracts against Escherichia coli strain isolated from diarrheic camel calvesSalma Bessalah1, Touhami Khorchani1, Mohamed Hammadi1, Asim Faraz2 and Ayman Balla Mustafa3*1Livestock and Wildlife Laboratory, Arid Lands Institute (IRA), University of Gabès, Médenine, Tunisia 2Department of Livestock and Poultry Production, Bahauddin Zakariya University, Multan, Pakistan 3Therapeutic Nutrition Department, Faculty of Health Sciences, Misurata University, Misurata, Libya *Corresponding Author: Ayman Balla Mustafa. Therapeutic Nutrition Department, Faculty of Health Sciences, Misurata University, Misurata, Libya. Email: a.yassien [at] nurs.misuratau.edu.ly Submitted: 02/06/2023 Accepted: 05/08/2023 Published: 30/09/2023 © 2023 Open Veterinary Journal
AbstractBackground: Camel calf’s diarrhea is considered the chief economic loss in the camelid population. There is currently no vaccine licensed to prevent colibacillosis in camel calves. The new era of bacterial antibiotic resistance explains the treatment failure and the high mortality and morbidity associated with the disease. Current protective treatments have thus far limited efficacy and need to be replaced. Due to their antimicrobial properties and safety, natural products are recently finding a capital role in infection management. Aims: The current study explores Escherichia coli F17 susceptibility as a clinical strain isolated from diarrheic camel calves to a wide panel of natural products. Methods: Agar diffusion method, integrity of cell membrane, hydrophobicity of bacterial surface, biofilm assays, and motility were used to evaluate the antibacterial activity of Coffea, Retama raetam, Moringa oleifera, Juniperus phoenicea, Uritica dioica, Camellia sinensis, Lavandula angustifolia, and Cuminum cyminum extracts against isolated bacteria. Results: Interestingly, all eight tested extracts have the damaging ability of E. coli F17’s cell membrane and cause the nucleic acid release after 12 hours. Escherichia coli F17 strain has the surface of hydrophobicity which changed after contact with extracts of the plant. Moreover, the motility of the studied bacteria changed after exposure to all plant extracts. Conclusion: This study demonstrated that all extracts, exempt U. dioica, can remove up to 50% biofilm of E. coli biomass as compared with the control. Natural extracts can be used as potential antimicrobial agents to mitigate diarrhea in camel calves. Keywords: E. coli, Camel calves, Diarrhea, Antibacterial, Hydrophobicity. IntroductionNeonatal diarrhea is still a leading disease in camel calves less than 3 months. The most critical phase of the camel production cycle has a great impact on it, and this one is the long-standing challenge in camelid husbandry practices (Mohammed et al., 2003). Apart from the multifactorial etiology including malnutrition, poor management practices, and no colostrum intake, camel calve diarrhea is often associated with infection with specific pathogens. In fact, epidemiological studies have indicated that the most common pathogen associated with camel calves’ diarrhea is Escherichia coli (E. coli) and its occurrence has been observed at a higher level in neonatal camel calves (Schwartz and Dioli, 1992; Salih et al., 1998). Previously, we identified E. coli expressing F17 fimbrial adhesin as the most predominant strain found in clinical isolates recovered from diarrheic camel calves (Bessalah et al., 2016). Fimbriae expressed by E. coli strains permit the bacterial attachment to target host cells via specific receptors and then the secretion of one or more enterotoxins which results in side effects of secretory diarrhea varying from slow growing to even acute death (Dubreuil et al., 2016). Currently, the common strategy to treat this type of infection is antibiotherapy. However, the American Centers for Disease Control and Prevention reported about the illnesses over 2 million related fungi and bacteria pathogens are at least resistant to a few classes of antimicrobials (Silva et al., 2016). The antibiotic-resistant bacteria has emergence explains the treatment failure and the high mortality and morbidity associated with the disease. On the other hand, therapy becomes more difficult due to the organism’s ability to organize the host into biofilms (Lewis, 2001; Corona and Martinez, 2013). Current protective treatments have thus far limited efficacy. In contrast to antibiotics, plant-derived compounds are economical, safe, and environmentally friendly antimicrobials. More importantly, plant-derived antibacterial compounds can possibly decrease the selective pressure on the development of antibiotic resistance. Currently, natural compounds exhibiting anti-bacterial activities are present in more than 70% of the pharmaceutical entities recognized by the Food and Drug Administration (Newman and Cragg, 2012). The properties of various plant-derived antimicrobials that target various microbial agents have been reported previously (Rios and Recio, 2005; Palou et al., 2017; Bonetti et al., 2020), but very few studies have highlighted the potential of natural compounds as an effective strategy for reducing the proliferation of diarrheic E. coli strains in camel calves. Coffea, Retama raetam, Moringa oleifera, Juniperus phoenicea, Uritica dioica, Camellia sinensis, Lavandula angustifolia, and Cuminum cyminum have been documented to exhibit appreciable properties of antibacterial activity (Gülçin et al., 2004; Almeida et al., 2006; Hayet et al., 2008; Elmhdwi et al., 2015; Osagie et al., 2021). Thus, the main purpose of the present study was the evaluation of the potential inhibitory effect of a panel of natural products against E. coli F17. More precisely, we investigated how these natural products could affect E. coli F17 growth, motility, membrane integrity, and biofilm formation. Material and MethodsPreparation of plant extractsThe aqueous extract was performed as recommended by Wojnicz et al. (2012) with the modification of slides. For each plant species, 5 g of dried leaf powder and 20 ml of distilled water were vortexed for 10 seconds. Then, the water bath (50°C ± 1°C) was used to heat the samples for 30 minutes with continuous shaking. Then, the mixer was centrifugated at 4,000 × g for 20 minutes. The pellets of the solution were discarded and the supernatant was filtered by whattman paper. Bacterial strains and culture conditionsAn E. coli strain originally isolated from a diarrheic camel calves of virotype: f17/afa/EastI/papC/iroN/iss/iucD, serogroup O64 was used in this study (Bessalah et al., 2016). The activation of frozen culture and its routine culturing in an LB broth (Difco, BD 244610) were practiced at aerobic conditions at 37°C. To maintain an active E. coli-F17 culture, a daily 1:100 passage was performed. Antibacterial activity analysisAgar diffusion method The agar method of disk diffusion was practiced according to previously reported studies (Oses et al., 2016). The bacteria were spread onto the agar plate surface with 106 CFU/ml density. Wells 5 mm in diameter were formed on LB plates using a micropipette and 100 μl of different extracts were loaded into every well. Then, the incubation of the plates was done for 18 hours at 37°C. The inhibition zone was measured in millimeters (mm). Ampicillin (100 μg/ml) was utilized as a positive reference standard. Bacterial growth assays The quantitative analysis of the antimicrobial activity was assessed in a liquid medium as previously reported by Wang et al. (2012). In brief, the dilution of overnight bacterial growth suspension has reached 0.1 at 600 nm absorbance value. Then, 0.1 ml of the material was dispensed/well into a microtiter plate of 96-well and incubated with different extracts at 37°C for 12 and 24 hours. At predetermined times, growth was determined using a microtiter enzyme-linked immunosorbent assay reader. All measurements have been carried out in triplicate. The percentage of bacterial inhibition was determined by the following equation: Bacterial inhibition (%)=Ic − Is / Ic * 100 where Is is the absorbance value of the bacterial suspension incubated with many extracts at each time and Ic is the absorbance value of the control bacterial suspension. Antibacterial mechanism of actionIntegrity of cell membrane The stream of nucleic acids (DNA and RNA) into the suspension of bacteria was performed following the methods described by Zhang et al. (2016) with slight modifications. Overnight cultures of E. coli (1 × 107 CFU/ml) were washed and suspended again in PBS (0.1 M, pH 7.4). The washed suspension of 3 ml was incubated with shaking for 4 hours at 37°C when variable plant extracts were present. Then, the harvesting of bacterial cells was completed by centrifugation for 15 minutes at 5,000 g. Consequently, the collection of supernatants and the absorption of released material at 260 and 280 nm were calculated by applying a UV–vis spectrophotometer. Determination of leakage of intracellular proteins The concentrations of proteins in supernatants were measured by Lowry et al.’s (1951) method using bovine albumin as a protein reference. Briefly, 100 μl of different samples were mixed with 100 μl of 2 N NaOH, then hydrolyzed the mixture in a boiling water bath for 10 minutes was done. Then, a complex forming reagent which was freshly prepared [1% w/v of CuSO4·5H2O, 2% w/v of sodium potassium tartrate, and 2% w/v of Na2CO3, in the proportion 100:1:1 (by vol.)] and has been added to every hydrolysate and then its incubation has been completed at room temperature for 10 minutes. Then, 100 μl of Folin reagent was mixed with the reaction and kept at room temperature for 30 minutes. Finally, the measurement of 750 nm absorbance along with the results was indicated as equivalent to bovine serum albumin. Motility assays The motility activities of E. coli were evaluated as described previously with slight modifications (Hidalgo et al., 2011). Briefly, a bacterial culture of about 5 μl (of approximately 108 CFU/ml) was co-incubated by various extracts on the central position of prepared soft LB-agar plates containing 0.5% agar and 0.8% glucose for 24 hours at 37°C. Then, the bacterial motility was measured in mm. Antibiofilm activity Biofilm formation and bacterial adhesion were performed in polystyrene plates of 96-well using the crystal violet assay (Elamary et al., 2021). Overnight cultures of E. coli were diluted in an LB medium of 0.05 OD600. Then, 100 μl aliquot of the bacterial cultures were mixed within every well and incubated for 24 hours without shaking at 37°C. Then, plant extract of about 50 μl was mixed, and the reincubation of the plates was completed for the next 24 hours. Three times washing of plates were done with sterile phosphate buffer (PBS) for the removal of planktonic bacteria, stained with 0.1% crystal violet for 5 minutes in 200 μl. Finally, microplates were washed again with PBS and the biofilm of crystal violet was diffused in ethanol and the rate of biofilm formation (%) was evaluated according to the following formula: Biofilm formation rate (%)=(ODsample/ODcontrol) × 100. A negative control (with LB alone) and a positive control (with bacteria alone) were also included in the experimental set. Evaluation of hydrophobicity at bacterial surface The effect of plant extracts on the hydrophobicity of the microbial surface was assessed according to Rosenberg et al. (1980) with a few modifications. Bacterial suspension, in the stationary phase, was centrifuged at 5,000 g for 15 minutes. Two times washing of the cells was done by using PBS buffer (0.1 M, pH 6.6) and adjusted to the optical density of 0.6 at 600 nm. 1 ml of Hexane, a nonpolar solvent, was mixed with the cell suspension of 2 ml and the mixture was vortexed for 2 minutes. The optical density of the supernatant, after being incubated for 1 hour at 37°C, was recorded at 600 nm and hydrophobicity was measured by using the following formula: Hydrophobicity (%)=(A0 − A1 / A0) × 100 where A0 and A1 are the absorbance value at 600 nm before and after the treatment with hexane, respectively. Ethical approvalNot required for this type of study. ResultsAgar diffusion method of antibacterial activityThe diameter of inhibition zones (DIZs) of different extracts detected by the disc diffusion method are shown in Figure 1. The zone of growth inhibition above 8 mm in diameter was considered a positive result Digvijay and Bhardwaj, 2017. It can be seen from Figure 1 that all extracts exhibited significant inhibitory effects against E. coli with the DIZ values of 15 mm for Coffea, U. dioica, and C. sinensis and 17 mm for M. oleifera, R. raetam, and J. phoenicea. L. angustifolia and C. cyminum showed the weakest antibacterial activity with a DIZs 12 mm. Antibacterial activity in liquid mediumIn a liquid medium, the antibacterial activity of natural extracts against E. coli-F17 was presented as bacterial growth inhibition at OD 600 nm at various incubation times. All extracts inhibit the bacterial cell growth effectively during the tested incubation time (Fig. 2). Of all extracts, U. dioica and C. sinensis showed the highest bacterial inhibition of 93.33% and 91.66%, respectively, after 24 hours incubation in E. coli suspensions. In contrast, C. cyminum did not show any antimicrobial activity against E. coli-F17 after 18 hours. However, its inhibition percentage reached 50% after 24 hours of incubation. Motility assaysThe impacts of natural extracts on E. coli-F17 swarming capacities are illustrated in Figure 3. For all natural extracts, more than 90% inhibition was noticed in the swarming motility of E. coli-F17 strain. Under control conditions (without extracts), E. coli-F17 exhibited proficient swarming motility (>50 mm diameter at 24 hours). The inhibitory effects were significant on the swarming motility of tested plant extracts. Our results demonstrated that swarming motility was decreased in different extracts from 7% to 39% in the analysis of the strains.
Fig. 1. Zone of growth inhibition after the treatment of E. coli-F17 with different extracts assessed with the inverted Petri dish method. 1: R. raetam; 2: C. cyminum; 3: J. phoenicea; 4: M. oleifera; 5: coffea; 6: U. dioica; 7: L. angustifolia; and 8: C. sinensis. Assessment of biofilm biomass level using crystal violet assayThe biofilm formation of E. coli-F17 in 96-well plates was determined in the presence of different plant extracts. As shown in Figure 4, it is clear that U. dioica and L. angustifolia extract remove the most biofilm biomass. While, when the bacteria is treated with C. cyminum and coffea extract, more than half of the cell clusters remain on the surface. In addition, the biofilm formation was not affected following growth in the presence of M. oleifera, C. sinensis, and J. phoeniea extracts. Integrity of cell membraneLeakage of nucleic acids The amount of nucleic acids (DNA and RNA) released from the E. coli-F17 culture treated with different plant extracts is shown in Figure 5. The UV absorption of E. coli-F17 treated with different extracts quickly increased in about 3 hours, except coffea extract. The O.D260 nm increased rapidly after 6 hours of incubation. The abilities of all eight tested extracts have damaged the E. coli F17’s cell membrane and the nucleic acid to be released. It is obviously seen that the content of DNA and RNA influenced by coffea and U. dioica extracts were higher than others at 6 hours. After 18 hours, OD260 nm values of all samples reached a steady state. Leakage of intracellular proteins The intracellular protein leakage from E. coli-F17 treated with various extracts was shown in Figure 6. In general, a rapid increase of protein concentration occurred in the supernatant of E. coli culture when incubated with different plant extracts. The highest release of intracellular protein by E. coli was obtained after 3 hours of incubation with M. oleifera. Furthermore, the releases of intracellular protein levels reach 4,105 and 4,031 after exposure to C. sinensis and U. dioica, respectively.
Fig. 2. Antibacterial activity of different plant extracts against E. coli-F17 after 18 and 24 hours. Data are mean ± SD for three measurements.
Fig. 3. Motility of E. coli-F17 on soft agar plates containing different plant extracts. Bacteria was inoculated at 37°C and photographed after 12 hours of incubation.
Fig. 4. Effects of plant extracts on the biofilm formation of E. coli-F17. The results are expressed as the mean ± SD of independent experiments.
Fig. 5. Release of 260-nm absorbing material (DNA and RNA) from E. coli-F17 treated with plant extracts. Hydrophobicity Bacterial surface hydrophobicity assay was generally used to explain the adhesive ability of bacteria in the gastrointestinal tract. Results of the hydrophobicity of E. coli-F17 strain against hexane are shown in Figure 7. The hydrophobicity percentage of E. coli-F17 decreased to 30%, 34%, and 34.8% after being exposed to C. cyminum, R. raetam, and coffea extract, while the values were 27.2% and 20.3% after treatment with U. dioica and L. angustifolia extract, respectively. On the other hand, when treated with M. oleifera, C. sinensis, and J. phoenicea extracts, the hydrophobic rate was 42%, 45%, and 44.5%, respectively.
Fig. 6. Leakage of proteins from E. coli-F17 when treated with different plant extracts.
Fig. 7. Hydrophobicity percentage of E. coli-F17 treated with different plant extracts in comparison with control (untreated bacteria). DiscussionMorbidity as well as mortality due to neonatal diarrhea becomes one of the leading causes among camel claves in less than 3 months causing massive havoc in livestock. Among the causative agents of this disease, E. coli was detected at a higher level (Bessalah et al., 2016; Shahein et al., 2021). Adhesion of E. coli to receptors present on the host cell is the first key step in the initiation of infection. Often this goal is achieved by fimbrial adhesins or pili which promote specific receptors binding on the host cell surfaces without the immediate need for cell–cell interaction. Escherichia coli expressing f17 gene, which encodes for F17 fimbriae was highly detected in neonatal camel calves (Bessalah et al., 2016). Several studies have reported that natural products can protect animals against a wide range of pathogens including E. coli (Dubreuil, 2020). Our study investigates the potential antibacterial effects of a panel of natural extracts against E. coli-F17 strain. Bacterial translocation is one of the major factors responsible for colonization and pathogenesis (O’May and Tufenkji, 2011). In the current investigation, we studied the impacts of natural extracts on the motility of E. coli-F17. Swarming motility is mainly involved in bacterial colonization and biofilm development (Costerton and Stewart, 1999; O’May and Tufenkji, 2011). Several researches have proved that different plant materials could decrease the motility of a vast range of pathogenic bacteria (Chow et al., 2011; Inamuco et al., 2012). It has been found that Mallotus japonica extract reduced EHEC swarming motility by disrupting the function of flagella (Lee et al., 2013). Reduced motility was also observed in E. coli when treated with Cranberry extracts (Hidalgo et al., 2011). Our results revealed that the motility of E. coli-F17 was drastically affected in the presence of all extracts. The decrease in swarming motility indicates that plant extracts can effectively alter bacterial adhesion and control biofilm maturation. In fact, swarming motility was found to inhibit the biofilm development of E. coli (Pratt and Kolter, 1998; Beloin et al., 2008; Wood, 2009). Interestingly, recent research has shown that decreased swarming motility was correlated with decreased quorum sensing which is defined as a chemical communication system employed by bacteria to support environmental stress and increase cell-population density (Daniels et al., 2004). The leakage of cell constituents (DNA, RNA, and proteins) was chosen as another aspect to elucidate the mechanism of antibacterial action as it plays an important role in the normal growth of bacteria. Intracellular macromolecular substances release can reflect the morphology of integrity and normal function of the cell membrane of bacteria. An important loss of intracellular contents means that the cytoplasmic membranes were irreversibly damaged which affects bacterial life activities (Wang et al., 2017). This study demonstrated that incubation of E. coli-F17 with selected plant extracts showed strong leakage of DNA and RNA materials after 6h, especially for R. raetam, J. phoenicea, L. angustifolia, and U. dioica extracts. Our result was in agreement with previous studies that reported that for Gram-negative bacteria, the antimicrobial substances can react rapidly with the outer membrane, and intracellular compounds were almost fully released which indicates bacterial death due to depletion of the nutrients (Bajpai et al., 2013). On the other hand, the difference between tested extracts can be explained by the difference in bioactive compound composition between selected plants. In fact, R. raetam contains a high percentage of polyunsaturated fatty acids, and notable contents of vitamin C with superior levels of total phenolic compounds (Saada et al., 2018). On the other hand, J. phoenicea contain several phenolic derivatives such as uslignans, bisflavones, and phenylpropane glycosides (Comte et al., 1997). Thus, we suggest compositional differences might be responsible for the different impacts detected between R. raetam, J. phoenicea, and other extracts on E. coli membrane integrity. Cell surface hydrophobicity is an important physicochemical property involved in bacterial physiology. Hydrophobicity was found to be positively correlated to bacterial adhesion (Saran et al., 2012). Our study revealed that after treatment with different plant materials, cell surface hydrophobicity in E. coli-F17 decreased significantly. The results of this study show that all extracts, exempt U. dioica, can remove up to 50% E. coli biomass biofilm in comparison to the control. The potential of M. oleifera and L. angustifolia extracts in eradicating preformed biofilms has been reviewed in some studies. For example, Zubair (2020) revealed the flesh extract of M. oleifera has antibacterial activity against Staphylococcus aureus and disrupts biofilm development. In another study, Ramić et al. (2021) analyzed the antibacterial and anti-biofilm potentials of L. angustifolia and demonstrated that essential oil was able to eradicate the biofilm formation of Campylobacter jejuni. Our research shows that J. phoenicea and R. raetam extract have some potential for biofilm biomass removal from surfaces since up to 90% of E. coli biofilm biomass could be removed. One reason can be that the R. raetam contains superior levels of bioactive compounds. To the best of our knowledge, this is the first report showing that J. phoenicea and R. raetam reduce E. coli biofilm formation. ConclusionIn conclusion, plant extracts used in this study showed strong suppression of swarming motility, hydrophobicity, and biofilm formation of E. coli-F17 isolated from neonatal camel calves. The present study suggests that these natural extracts have potential uses in colibacillosis mitigation in camel calves. AcknowledgmentNot applicable. Authors contributionsThis research was conceptualized by Salma Bessalah. The study was co-authored by all authors. The final manuscript was read and approved by all authors. Conflicts of interestThe authors declare that there is no conflict of interest. FundingThis research did not receive any specific funding. Data availabilityThe data supporting the findings of this study are available within the manuscript. Any other data are available from the corresponding author upon reasonable request. ReferencesAlmeida, A.A.P., Farah, A., Silva, D.A., Nunan, E.A. and Glória, M.B.A. 2006. Antibacterial activity of coffee extracts and selected coffee chemical compounds against enterobacteria. J. Agric. Food Chem. 54, 8738–8743. Bajpai, V.K., Sharma, A. and Baek, K.H. 2013. Antibacterial mode of action of Cudraniatri cuspidata fruit essential oil, affecting membrane permeability and surface characteristics of food-borne pathogens. Food Control 32, 582–590. Beloin, C., Roux, A. and Ghigo, J.M. 2008. Escherichia coli biofilms. Curr. Top. Microbiol. Immunol. 322, 249–289. Bessalah, S., Fairbrother, J.M. and Salhi, I. 2016. Antimicrobial resistance and molecular characterization of virulence genes, phylogenetic groups of Escherichia coli isolated from diarrheic and healthy camel-calves in Tunisia. Comp. Immunol. Microbiol. Infect. Dis. 49, 1–7. Bonetti, A., Tugnoli, B., Rossi, B., Giovagnoni, G., Piva, A. and Grilli, E. 2020. Nature-identical compounds and organic acids reduce E. coli K88 growth and virulence gene expression in vitro. Toxins (Basel) 12, 468. Chow, S., Gu, K., Jiang, L. and Nassour, A. 2011. Salicylic acid affects swimming, twitching and swarming motility in Pseudomonas aeruginosa, resulting in decreased biofilm formation. J. Exp. Microbiol. Immunol. 15, 22–29. Comte, G., Vercauteren, J., Chulia, A.J., Allais, D.P. and Delage, C. 1997. Phenyl propanoids from leaves of Juniperus phoenicea. Phytochemistry 45, 1679–1682. Corona, F. and Martinez, J.L. 2013. Phenotypic resistance to antibiotics. Antibiotics 2, 237–255. Costerton, J.W. and Stewart, P.S. 1999. Greenberg bacterial biofilms: a common cause of persistent infections. Science 284, 1318–1322. Daniels, R., Vanderleyden, J. and Michiels, J. 2004. Quorum sensing and swarming migration in bacteria. FEMS Microbiol. Rev. 28, 261–289. Digvijay, S. and Bhardwaj, S.V. 2017. In vitro antibacterial studies on essential oils from Juniperus communis. L. J. Chem. Pharm. Res. 9, 37–42. Dubreuil, J.D. 2020. Fruit extracts to control pathogenic Escherichia coli: a sweet solution. Heliyon 6, e03410. Dubreuil, J.D., Isaacson, R.E. and Schifferli, D.M. 2016. Animal enterotoxigenic Escherichia coli. EcoSal Plus 7(1), 10. Elamary, R.B., Wahba, M., Sayed, W.F. and Salem, W.M. 2021. Efficiency of certain vegetables under various storage conditions against the meat-borne Escherichia coli isolates. Int. J. Environ. Sci. Technol. 19, 7869–7884. Elmhdwi, F., Attitalla, H. and Khan, A. 2015. Evaluation of antibacterialactivity and antioxidant potential of different extracts from the leaves of Juniperus phoenicea. J. Plant Pathol. Microbiol. 6(9), 1–8. Gülçin, I., Küfrevioǧlu, Ö.I., Oktay, M. and Büyükokuroǧlu, M.E. 2004. Antioxidant, antimicrobial, antiulcer and analgesicactivities of nettle (Urtica dioica L.). J. Thnopharmacol. 90, 205–215. Hayet, E., Maha, M., Samia, A., Mata, M., Gros, P. and Raida, H. 2008. Antimicrobial, antioxidant, and antiviral activities of Retama raetam (Forssk.) Webb flowers growing in Tunisia. World J. Microb. Biotech. 24, 2933–2940. Hidalgo, G., Chan, M. and Tufenkji, N. 2011. Inhibition of Escherichia coli CFT073 fliC expression and motility by cranberry materials. Appl. Environ. Microbiol. 77, 6852–6857. Inamuco, J., Veenendaal, A.K., Burt, S.A., Post, J.A., Tjeerdsma-van Bokhoven, J.L., Haagsman, H.P. and Veldhuizen, E.J. 2012. Sub-lethallevels of carvacrolreduce Salmonella typhimurium motility and invasion of porcine epithelialcells. Vet. Microbiol. 157, 200–207. Lee, J.H., Cho, H.S., Joo, S.W., Regmi, S.C., Kim, J.A., Ryu, C.M., Ryu, S.Y., Cho, M.H. and Lee, J. 2013. Diverse plant extracts and trans-resveratrol inhibit biofilm formation and swarming of Escherichia coli O157:H7. Biofouling 29, 1189–1203. Lewis, K. 2001. Riddle of biofilm resistance. Antimicrob. Agents Chemother. 45, 999–1007. Lowry, O.H., Rosebrough, N.J., Farr, A.L. and Randall, R.J. 1951. Protein measurement with the Folin phenol reagent. J. Biol. Chem. 193, 265–275. Mohammed, M.E., Hart, C.A. and Kadden, O.R. 2003. Viruses and bacteria associated with neonated camel calf diarrhea in eastern Sudan. Emirate J. Agric. Sci. 15, 56–62. Newman, D.J. and Cragg, G.M. 2012. Natural products as sources of new drugs over the 30 years from 1981 to 2010. J. Nat. Prod. 75, 311–335. O’May, C. and Tufenkji, N. 2011. The swarmingmotility of Pseudomonas aeruginosa is blocked by cranberry proanthocyanidins and other tannin-containing materials. Appl. Environ. Microbiol. 77, 3061–3067. Osagie, E.A., Osayemwenre, E., Udogadi, N.S. and Olalekan, S.H. 2021. Action of fractionated Moringa oleifera Lam leaf extracts on multidrug resistant Pseudomonas aeruginosa strains. Int. J. Clin. Exper. Med. Res. 5(3), 316–329. Oses, S.M., Pascual-Mate, A., de la Fuente, D., de Pablo, A., Fernandez-Muino, M.A. and Sancho, M.T. 2016. Comparison of methods to determine antibacterial activity of honeys against Staphylococcus aureus. NJAS Wagening J. Life Sci. 78, 29–33. Palou, R., Turni, C. and Roura, E. 2017. In vitro antimicrobial activity of essential oils against enterotoxigenic Escherichia coli found in a nation-wide commercial farm survey. Anim. Prod. Sci. 57, 2506. Pratt, L.A. and Kolter, R. 1998. Genetic analysis of Escherichia coli biofilm formation: roles of flagella, motility, chemotaxis and type I pili. Mol. Microbiol. 30, 285–293. Ramić, D., Bucar, F., Kunej, U., Dogša, I., Klančnik, A. and SmoleMožina, S. 2021. Antibiofilm potential of Lavandula preparations against Campylobacter jejuni. Appl. Environ. Microbiol. 87, e0109921. Rios, J.L. and Recio, M.C. 2005. Medicinal plants and antimicrobial activity. J. Ethnopharmacol. 100, 80–84. Rosenberg, M., Gutnick, D. and Rosenberg, E. 1980. Adherence of bacteria to hydrocarbons a simple method for measuring cell-surface hydrophobicity. FEMS Microbiol. Lett. 9, 29–33. Saada, M., Falleh, H., Catarino, M.D., Cardoso, S.M. and Ksouri, R. 2018. Plant growth modulates metabolites and biological activities in Retama raetam (Forssk.) Webb. Molecules. 23, 2177. Salih, O.M., Shigidi, H.O. and Mohamed, Y. 1998. The bacterial causes of camel-calf diarrhea in Eastern Sudan. In Proceedings of the Third Annual Meeting for Animal Production 2, United Arab Emirates University, Al Ain, UAE, pp: 132–137. Saran, S., Bisht, M.S., Singh, K. and Teotia, U.V.S. 2012. Comparing adhesion attributes of two isolates of Lactobacillus acidophilus for assessment of prebiotics, honey and inulin. Int. J. Sci. Res. 21, 2250–3153. Schwartz, H.J. and Dioli, M. 1992. The one-humped camel Eastern Africa—a pictorial guide to health disease care and management. Berlin, Germany: Verlag Josef Margraf. Shahein, M.A., Dapgh, A.N., Kamel, E., Ali, S.F., Khairy, E.A., Abuelhag, H.A. and Hakim, A.S. 2021. Advanced molecular characterization of enteropathogenic Escherichia coli isolated from diarrheic camel neonates in Egypt. Vet. World 14, 85. Silva, L.N., Zimmer, K.R., Macedo, A.J. and Trentin, D.S. 2016. Plant natural products targeting bacterial virulence factors. Chem. Rev. 116, 9162–9236. Wang, F., Wei, F., Song, C., Jiang, B., Tian, S. and Yi, J. 2017. Dodartia orientalis L. essential oil exerts antibacterial activity by mechanisms of disrupting cell structure and resisting biofilm. Ind. Crops Prod. 109, 358–366. Wang, S., Zheng, F., Huang, Y., Fang, Y., Shen, M., Zhu, M. and Shi, X. 2012. Encapsulation of amoxicillin with inlaponite-doped poly (lactic-co-glycolic acid) nano fibers: preparation, characterization, and antibacterial activity. ACS Appl. Materials Interface 4, 6393–6401. Wojnicz, D., Kucharska, A.Z., Sokół-Łętowska, A., Kicia, M. and Tichaczek-Goska, D. 2012. Medicinal plants extracts affect virulence factors expression and biofilm formation by the uropathogenic Escherichia coli. Urol. Res. 40, 683–697. Wood, T.K. 2009. Insights on Escherichia coli biofilm formation and inhibition from whole-transcriptome profiling. Environ. Microbiol. 11, 1–15. Zhang, Y.B., Liu, X.Y., Wang, Y.F., Jiang, P.P. and Quek, S.Y. 2016. Antibacterial activity and mechanism of cinnamon essential oil against Escherichia coli and Staphylococcus aureus. Food Control. 59, 282–289. Zubair, M. 2020. Antimicrobial and anti-Biofilm activities of Citrus sinensis and Moringa oleifera against the pathogenic Pseudomonas aeruginosa and Staphylococcus aureus. Cureus 12(12), e12337. | ||
| How to Cite this Article |
| Pubmed Style Bessalah S, Khorchani T, Hammadi M, Faraz A, Mustafa AB. Inhibitory potential of natural plant extracts against Escherichia coli strain isolated from diarrheic camel calve. Open Vet. J.. 2023; 13(9): 1082-1090. doi:10.5455/OVJ.2023.v13.i9.3 Web Style Bessalah S, Khorchani T, Hammadi M, Faraz A, Mustafa AB. Inhibitory potential of natural plant extracts against Escherichia coli strain isolated from diarrheic camel calve. https://www.openveterinaryjournal.com/?mno=154563 [Access: January 25, 2026]. doi:10.5455/OVJ.2023.v13.i9.3 AMA (American Medical Association) Style Bessalah S, Khorchani T, Hammadi M, Faraz A, Mustafa AB. Inhibitory potential of natural plant extracts against Escherichia coli strain isolated from diarrheic camel calve. Open Vet. J.. 2023; 13(9): 1082-1090. doi:10.5455/OVJ.2023.v13.i9.3 Vancouver/ICMJE Style Bessalah S, Khorchani T, Hammadi M, Faraz A, Mustafa AB. Inhibitory potential of natural plant extracts against Escherichia coli strain isolated from diarrheic camel calve. Open Vet. J.. (2023), [cited January 25, 2026]; 13(9): 1082-1090. doi:10.5455/OVJ.2023.v13.i9.3 Harvard Style Bessalah, S., Khorchani, . T., Hammadi, . M., Faraz, . A. & Mustafa, . A. B. (2023) Inhibitory potential of natural plant extracts against Escherichia coli strain isolated from diarrheic camel calve. Open Vet. J., 13 (9), 1082-1090. doi:10.5455/OVJ.2023.v13.i9.3 Turabian Style Bessalah, Salma, Touhami Khorchani, Mohamed Hammadi, Asim Faraz, and Ayman Balla Mustafa. 2023. Inhibitory potential of natural plant extracts against Escherichia coli strain isolated from diarrheic camel calve. Open Veterinary Journal, 13 (9), 1082-1090. doi:10.5455/OVJ.2023.v13.i9.3 Chicago Style Bessalah, Salma, Touhami Khorchani, Mohamed Hammadi, Asim Faraz, and Ayman Balla Mustafa. "Inhibitory potential of natural plant extracts against Escherichia coli strain isolated from diarrheic camel calve." Open Veterinary Journal 13 (2023), 1082-1090. doi:10.5455/OVJ.2023.v13.i9.3 MLA (The Modern Language Association) Style Bessalah, Salma, Touhami Khorchani, Mohamed Hammadi, Asim Faraz, and Ayman Balla Mustafa. "Inhibitory potential of natural plant extracts against Escherichia coli strain isolated from diarrheic camel calve." Open Veterinary Journal 13.9 (2023), 1082-1090. Print. doi:10.5455/OVJ.2023.v13.i9.3 APA (American Psychological Association) Style Bessalah, S., Khorchani, . T., Hammadi, . M., Faraz, . A. & Mustafa, . A. B. (2023) Inhibitory potential of natural plant extracts against Escherichia coli strain isolated from diarrheic camel calve. Open Veterinary Journal, 13 (9), 1082-1090. doi:10.5455/OVJ.2023.v13.i9.3 |